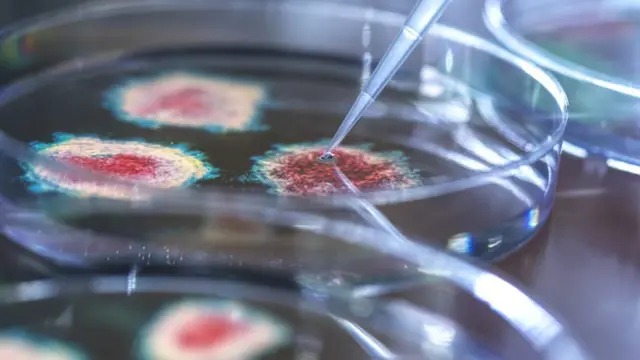
பாக்டீரியா - கோப்புப் படம்

கிருமி ஆயுதம்: 1933ல் இந்தியாவில் நடந்த ஜமீன்தார் கொலை - உலகம் கவனித்த வழக்கு

- எழுதியவர், செளதிக் பிஸ்வாஸ்
- பதவி, பிபிசி இந்தியா செய்தியாளர்
1933 நவம்பர் 26ஆம் தேதி மதியம், உருவத்தில் சிறிய மனிதர் ஒருவர், ஓர் இளம் ஜமீன்தாரை கொல்கத்தா (அன்று கல்கத்தா) ரயில் நிலையத்தில் சட்டென உரசிச் சென்றார்.
20 வயதான அமரேந்திர சந்திர பாண்டேவின் வலது கையில் ஊசி குத்தியது போல ஒருவித வலி ஏற்பட்டது. காதி ஆடை அணிந்திருந்த அந்த மனிதர் ஹவுரா ரயில் நிலையத்தில் கூட்டத்தோடு கூட்டமாக கரைந்து போனார்.
"யாரோ என்னைக் குத்தி இருக்கிறார்கள்" என ஆச்சர்யப்பட்டுக் கொண்டு, தற்போது ஜார்கண்ட் மாநிலத்தில் ஒரு பகுதியாக இருக்கும் பாகூர் மாவட்டத்தில் உள்ள தனது குடும்ப வீட்டுக்கான பயணத்தைத் தொடர தீர்மானித்தார் அமரேந்திரா.
அமரேந்திரா உடனிருந்த சொந்தபந்தங்கள் ரத்தப் பரிசோதனை மேற்கொள்ளுமாறும், அங்கேயே தங்குமாறும் கூறினர். ஆனால் அமரேந்திராவை விட 10 வயது மூத்தவரான பினொயேந்திரா, யாரும் அழைக்காமல் ரயில் நிலையத்துக்கு வந்த போது சம்பவத்தை பெரிதாக எடுத்துக் கொள்ளாமல், தாமதமின்றி பயனத்தைத் தொடர வலியுறுத்தினார்.
மூன்று நாட்கள் கழித்து, காய்ச்சலோடு கொல்கத்தா திரும்பினார் அமரேந்திரா. அவரை பரிசோதித்த மருத்துவர், அவரை குத்தியதாக கருதப்படும் இடத்தில் ஹைபோடெர்மிக் ஊசி குத்தப்பட்டது போன்ற தடத்தைக் கண்டார்.
அடுத்த சில நாட்களில் அவரது காய்ச்சல் அதிகரித்தது, அவரது அக்குள் பகுதியில் வீக்கம் ஏற்பட்டது, அதோடு நுரையீரல் நோய்க்கான ஆரம்பகால சமிக்ஞைகள் வெளிப்பட்டன. டிசம்பர் 3ஆம் தேதி அமரேந்திரா கோமாவுக்குச் சென்றுவிட்டார். அடுத்த நாள் காலை அவர் உயிர் பிரிந்தது.
அமரேந்திரா நிமோனியாவால் இறந்ததாக மருத்துவர்கள் சான்றளித்தனர். ஆனால் அவர் மரணத்துக்குப் பின் வந்த ஆய்வறிக்கை, அவர் ரத்தத்தில் யெர்சினியா பெஸ்டிஸ் (Yersinia pestis) என்கிற அபாயகரமான பாக்டீரியா இருந்ததாக கூறியது. இந்த பாக்டீரியா தான் பிளேக் நோய்க்கு காரணம் என்பது குறிப்பிடத்தக்கது.
இந்த பாக்டீரியா எலிகள் மற்றும் ஃப்ளீஸ் என்றழைக்கப்படும் சிறிய பூச்சிகளின் மூலம் பரவும். பிளேக் நோயால் இந்தியாவில் 1896 முதல் 1918 வரை சுமார் 1.20 கோடி பேர் உயிரிழந்தனர்.
1929 முதல் 1938 ஆண்டுகளுக்கு இடையில் பிளேக் நோயால் இறந்தவர்களின் எண்ணிக்கை ஐந்து லட்சமாகக் குறைந்தது, அமரேந்திராவின் இறப்புக்கு முன்வரை, மூன்றாண்டுகளுக்கு கொல்கத்தாவில் ஒருவர் கூட பிளேக் நோயால் பாதிக்கப்படவில்லை.
சொத்து பத்துக்களோடு வாழ்ந்து வந்த ஜமீன்தார் குடும்பத்தில் நடந்த இந்த பரபரப்பான கொலை பிரிட்டிஷ் இந்தியாவைத் தாண்டி உலகம் முழுக்க பரவியது. "நவீன உலக வரலாற்றில் தனிப்பட்ட முறையில் நடத்தப்பட்ட முதல் உயிரி பயங்கரவாதம்" என இச்சம்பவத்தை ஒருவர் விவரித்தார்.

பட மூலாதாரம், EASTERN RAILWAY
பல பத்திரிகைகளும் இந்த கொலை வழக்கை உன்னிப்பாகப் பின்தொடர்ந்து வந்தன. "கிருமிகளைக் கொண்டு நடத்தப்பட்ட கொலை" என டைம் பத்திரிகை இச்சம்பவத்தை விவரித்தது, "துளையிடப்பட்ட கை மர்மம்" என சிங்கப்பூரின் ஸ்ட்ரெயிட் டைம்ஸ் பத்திரிகை கூறியது.
இக்கொலையை விசாரித்த கொல்கத்தா காவல்துறை ஒரு சிக்கலான சதித் திட்டத்தை வெளிக் கொண்டு வந்தது. இதில் அன்றைய பம்பாயின் ஒரு மருத்துவமனையிலிருந்து பாக்டீரியாவைக் கொண்டு வந்ததும் அடக்கம்.
இந்த கொலைக்கு குடும்ப பங்காளிச் சண்டைதான் காரணமாக இருந்ததும் தெரியவந்தது.
நிலக்கரி சுரங்கங்கள் மற்றும் கல் குவாரிகள் நிறைந்த பாகூர் மாவட்டத்தில் உள்ள, அவர்களது தந்தைக்குச் சொந்தமான பெரிய வீடு தொடர்பாக பாண்டே சகோதரர்கள் (அமரேந்திரா மற்றும் பினொயேந்திரா) இரண்டு ஆண்டுகளாக மோதிக் கொண்டுவந்தனர். இந்த சண்டை சச்சரவு தொடர்பில், பிரபல ஊடகங்களில் ஒருவர் நல்லவராகவும் மற்றொருவர் கெட்டவராகவும் சித்தரிக்கப்பட்டு செய்திகள் வெளியாயின.
அமரேந்திரா நல்ல மனிதர், உயர்ந்த குணநலன்களைக் கொண்டவர், உயர் கல்வி பயில விரும்புபவர், உடல் நலத்தைப் பேணிக் காப்பதில் ஆர்வம் கொண்டவர், உள்ளூர் மக்களால் அதிகம் நேசிக்கப்படக் கூடியவர் என்றும், பினொயேந்திரா மது, மாது என சுக போகங்களில் திளைப்பவர் என ஒரு தரப்பு குறிப்பிட்டது.
1932ஆம் ஆண்டே அமரேந்திராவைக் கொலை செய்ய திட்டம் தீட்டப்பட்டதாக நீதிமன்ற ஆவணங்கள் கூறுகின்றன. மருத்துவர் தாராநாத் பட்டாசார்யா என்கிற பினொயேந்திராவின் நண்பர், ஒரு மருத்துவ ஆய்வகத்திலிருந்து பிளேக் கிருமியை எடுக்க எடுத்த முயற்சிகள் தோல்வியில் முடிந்தது என அந்த ஆவணங்கள் கூறுகின்றன.

பட மூலாதாரம், CULTURE CLUB/GETTY IMAGES
1932ஆம் ஆண்டு கோடை காலத்திலேயே பினொயேந்திரா தன் சகோதரரை கொலை செய்ய முயற்சித்ததாக மற்ற சில தரப்புகள் கூறுகின்றன என்றாலும், அது சர்ச்சைக்கு உட்பட்டது.
இருவரும் ஒரு மலைப் பிரதேசத்தில் ஒரு ஆசுவாச நடைக்குச் சென்ற போது, பினொயேந்திரா தயாரித்திருந்த கண்ணாடியை, அவரது சகோதரரை அணியச் செய்து, மூக்கு பகுதியில் காயம் ஏற்படுத்தியதாக, பிரிட்டிஷ் சுகாதார அதிகாரி டி பி லேம்பர்ட்டின் அறிக்கை கூறுகிறது.
அதற்குப் பின் அமரேந்திராவுக்கு உடனடியாக உடல் நலக் குறைவு ஏற்பட்டது. அமரேந்திராவுக்கு அணிவிக்கப்பட்ட கண்ணாடியில் கிருமி இருந்ததாகச் சந்தேகம் எழுந்தது. அமரேந்திராவுக்கு டெடானஸ் இருப்பது கண்டுபிடிக்கப்பட்டது, அவருக்கு டெடானஸ் சீரம் கொடுக்கப்பட்டது. அமரேந்திராவின் மருத்துவ சிகிச்சையை மாற்ற பினொயேந்திரா மூன்று மருத்துவர்களை அழைத்து வந்ததாகக் கூறப்படுகிறது. ஆனால் அம்மருத்துவர்களுக்கு அனுமதி மறுக்கப்பட்டதாக லாம்பர்ட்டின் அறிக்கை கூறுகிறது.
அடுத்த ஆண்டு நடந்த சதித்திட்டம், அப்போதைய கால கட்டத்தில் காணப்படாத, மிகவும் முன்னேறிய ஒன்றாக இருந்தது.
பினொயேந்திராவுக்கு வீடு கிடைத்தது, அதே நேரத்தில் அவரது மருத்துவர் நண்பர் தாராநாத் பட்டாச்சார்யா குறைந்தபட்சம் நான்கு முறையாவது பிளேக் கிருமியை பெற முயற்சித்தார்.
1932 மே மாதம், தாராநாத் மும்பையில் இருந்த ஹாஃப்கின் நிறுவனத்தின் இயக்குநரைத் தொடர்பு கொண்டார். இந்தியாவிலேயே பிளேக் கிருமிகளை வைத்திருந்த ஒரே ஆய்வகம் அதுதான். வங்காளத்தின் சர்ஜன் ஜெனரலின் அனுமதியின்றி, பிளேக் கிருமிகளை வழங்க முடியாது என மறுத்துவிட்டார் அந்த ஆய்வகத்தின் இயக்குநர்.
அதே மாதம், தாராநாத் கொல்கத்தாவில் இருந்த வேறொரு மருத்துவரைத் தொடர்பு கொண்டு, தான் பிளேக் நோய்க்கு மருந்து கண்டுபிடித்துவிட்டதாகவும், அதை பிளேக் பாக்டீரியாவை வைத்து பரிசோதிக்க விரும்புவதாகவும் கூறினார். ஆய்வகத்தில் தாராநாத் பணியாற்ற அனுமதித்த அம்மருத்துவர், ஹாஃப்கின் நிறுவனத்திலிருந்து கொண்டு வரப்பட்ட பிளேக் பாக்டீரியாவைக் கையாள அனுமதிக்கவில்லை என நீதிமன்ற ஆவணங்கள் கூறுகின்றன. பிளேக் பாக்டீரியா ஆய்வகத்தில் வளராததால், பரிசோதனைகள் முடிவுக்கு வந்ததாக மருத்துவர் லாம்பர்ட்டின் தரப்பு கூறுகிறது.

பட மூலாதாரம், WELLCOME TRUST
தாராநாத் விட்டபாடில்லை, 1933ஆம் ஆண்டு மீண்டும் அம்மருத்துவரைத் தொடர்பு கொண்டு ஹாஃப்கின் நிறுவன இயக்குநருக்கு கடிதம் எழுதுமாரு வற்புறுத்தினார். அதில், தாராநாத் பிளேக் மருந்தை பரிசோதிக்க ஹாஃப்கின் நிறுவனத்தின் கட்டமைப்புகளை பயன்படுத்திக் கொள்ள அனுமதிக்குமாறு குறிப்பிட்டிருந்தார்.
அந்த ஆண்டு கோடை காலத்தில் பினொயேந்திரா மும்பைக்குச் சென்றார். அங்கு தாராநாத்தோடு இணைந்து, பிளேக் பாக்டீரியாவைக் கடத்த, ஹாஃப்கின் நிறுவனத்தைச் சேர்ந்த விலங்குகளுக்கான அறுவை சிகிச்சை மருத்துவர்கள் இருவருக்கு லஞ்சம் கொடுத்தார்.
பினொயேந்திரா சந்தைக்குச் சென்று சில எலிகளை வாங்கி வந்தார். தங்களை உண்மையான விஞ்ஞானிகளைப் போல காட்டிக் கொள்ள அதைப் பயன்படுத்திக் கொண்டார். பிறகு பிளேக் பாக்டீரியா சேமித்து வைக்கப்பட்டிருந்த ஆர்தர் ரோட் தொற்று நோய் மருத்துவமனைக்குச் சென்றனர்.
அங்கு, தன் மருத்துவர் நண்பர் கண்டுபிடித்ததாகக் கூறப்பட்ட மருந்தை ஆய்வகத்தில் வைத்துப் பரிசோதிக்க அனுமதிக்குமாறு அதிகாரிகளிடம் வலியுறுத்தியதாக நீதிமன்ற ஆவணங்கள் கூறுகின்றன. ஆனால் ஆய்வகத்தில் அவர் எந்த ஆய்வுகளையும் மேற்கொண்டதற்கான ஆதாரங்கள் இல்லை. ஆய்வகத்தைப் பயன்படுத்திக் கொள்ள அனுமதி கொடுக்கப்பட்டு ஐந்து நாட்களுக்குப் பிறகு, ஜூலை 12ஆம் தேதி தன் பணிகளை எல்லாம் முடித்துக் கொண்டு, கொல்கத்தா திரும்பினார் பினொயேந்திரா.
1934ஆம் ஆண்டு பிப்ரவரி மாதத்தில் காவல்துறை, கொலை நடந்து சுமார் மூன்று மாதங்களுக்குப் பிறகு அவரை கைது செய்தனர். பினொயேந்திராவின் பயண விவரங்கள், மும்பையில் அவர் தங்கியிருந்த விடுதி ரசீதுகள், அவர் கைப்பட எழுதிய விடுதிப் பதிவு, ஆய்வகத்துக்கு அவர் எழுதிய விவரங்கள், அவர் சந்தையில் எலிகளை வாங்கிய கடையின் ரசீது என பல விவரங்களை இக்கொலையை விசாரித்த அதிகாரிகள் கண்டுபிடித்தனர்.
சுமார் ஒன்பது மாத காலம் நடந்த இந்த கொலைக்குற்ற விசாரணை, பலவகைகளில் பலரின் கவனத்தை ஈர்ப்பதாக இருந்தது. அமரேந்திரா ரேட் ஃப்ளீ என்றழைக்கப்படும் பூச்சி கடித்து பாதிக்கப்பட்டார் என வாதாடியது பினொயேந்திராவின் தரப்பு.
பட மூலாதாரம், Getty Images
பினொயேந்திரா மற்றும் தாராநாத் மும்பை மருத்துவமனையிலிருந்து பிளேக் கிருமியை திருடியதாக ஆதாரங்கள் நிரூபிப்பதாகவும், அதை கொல்கத்தாவுக்கு கொண்டு வந்து 1933 நவம்பர் 26ஆம் தேதி (அமரேந்திரா உடலில் பிளேக் செலுத்தப்பட்ட நாள்) வரை உயிர்ப்போடு வைத்திருந்திருக்கலாம் என்றும் கூறியது நீதிமன்றம்.
நீதிமன்ற விசாரணையில் பினொயேந்திரா மற்றும் தாராநாத், கூலிப் படை கொண்டு அமரேந்திராவைக் கொல்ல சதித்திட்டம் தீட்டியதாகக் கூறி அவர்களுக்கு மரண தண்டனை விதித்தது. மேல்முறையீடு செய்யப்பட்ட இந்த வழக்கில் 1936 ஜனவரியில், கொல்கத்தா உயர் நீதிமன்றம், அவர்களின் மரண தண்டனையை ஆயுள் தண்டனையாகக் குறைத்தது. இந்த வழக்கு தொடர்பாக கைது செய்யப்பட்டமற்ற இரு மருத்துவர்கள், போதிய ஆதாரங்கள் இல்லை என்று கூறி விடுவிக்கப்பட்டனர். "குற்ற வரலாற்றில் இது ஒரு தனித்துவமான வழக்கு" என மேல்முறையீட்டில் இவ்வழக்கை விசாரித்த ஒரு நீதிபதி குறிப்பிட்டார்.
பினொயேந்திரா 20ஆம் நூற்றாண்டைச் சேர்ந்த மனிதர், அவர் விக்டோரிய நிறுவனங்களைக் கடந்து பெரிதாக சாதிக்க முடியும் என்கிற எண்ணத்தில் இருந்தார் என தி பிரின்ஸ் அண்ட் தி பாய்சனர் என்கிற புத்தகம் தொடர்பாக ஆராய்ந்து வரும் அமெரிக்க பத்திரிகையாளர் டேன் மோரிசன் என்னிடம் கூறினார். ரயில் நிலையத்தில் நடத்தப்பட்ட கொலை முயற்சி முற்றிலும் ஒரு நவீனமானது என்றும் குறிப்பிட்டார் மோரிசன்.
உலகில் கிமு ஆறாம் நூற்றாண்டிலிருந்து உயிரி ஆயுதங்கள் பயன்படுத்தப்பட்டு வருகின்றன. அசிரியர்கள் தங்கள் எதிரிகளின் கிணறுகளை, ரை எர்காட் (Rye Ergot) என்கிற ஒருவித பூஞ்சை நோயைக் கொண்டு பாழ்படுத்தினர். பல வழிகளில் அமரேந்திராவின் கொலை கிம் ஜாங் உன்னின் சகோதரர் கிம் ஜாங் நம்மின் கொலையை பிரதிபலிப்பதாக இருக்கிறது.
2017ஆம் ஆண்டு, கிம் ஜாங் நம் கோலாலம்பூரில் ஒரு விமானத்துக்காகக் காத்திருந்த போது, இரண்டு பெண்கள் அவர் முகத்தில் ஒரு வித வேதிப் பொருளைத் தடவியதில் அவர் உயிரிழந்ததாக கூறப்பட்டது.
88 ஆண்டுகளுக்கு முன் இன்றைய கொல்கத்தா, கல்கத்தாவாக இருந்த போது ஹவுரா ரயில் நிலையத்தில் அமரேந்திராவைக் கொலை செய்ய பயன்படுத்தப்பட்ட ஹைபோடெர்மிக் ஊசி இன்று வரை கண்டுபிடிக்கப்படவில்லை.
பிற செய்திகள்:
- "இந்தியைத் திணித்தால் கட்டாயம் எதிர்ப்போம். அதில் சமரசமே கிடையாது": அண்ணாமலை
- ஒமிக்ரான் தொற்று: எந்தெந்த அறிகுறிகள் இருந்தால் கவனம் தேவைப்படும்?
- திருமணத்துக்கு சம்மதிக்கவில்லை என இளம்பெண்ணை கொலை செய்த மூன்று திருமணமான நபர்
- 1933ல் கிருமி ஆயுதத்தை பயன்படுத்தி இந்தியாவில் நடந்த கொலை - உலகம் கவனித்த வழக்கு
- இளவரசி ஹயா, துபாய் ஷேக், ரூ.5,500 கோடிக்கு ஜீவனாம்சம் - மலைப்பூட்டும் விவாகரத்து வழக்கின் தீர்ப்பு
சமூக ஊடகங்களில் பிபிசி தமிழ்:
- ஃபேஸ்புக் : பிபிசி தமிழ் ஃபேஸ்புக்
- டிவிட்டர் : பிபிசி தமிழ் ட்விட்டர்
- இன்ஸ்டாகிராம் : பிபிசி தமிழ் இன்ஸ்டாகிராம்
- யு டியூப் : பிபிசி தமிழ் யுடியூப்












